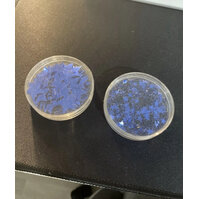

> 500 Angebote gefunden
Trevor Noah kam 1984 im Township Soweto als Sohn einer Xhosa und eines Schweizers zur Welt. Zu einer Zeit, da das südafrikanische Apartheidsregime ... mehr
heifleiflei | 17.11.2025
Tickets:
3
Dean Martin, Jerry Lewis, Polly Bergen, Mike Kellin, Tommy Farrell, Dick Stabile, Jimmie Dundee
Blu-ray (2019)
Der Koreakrieg ist im Gange und in einem Trainingscamp der US-Army warten die Einsatzkräfte darauf, nach Korea eingeschifft zu werden. Zum Leidwesen ... mehr
hamsterf77 | 17.11.2025
Tickets:
2